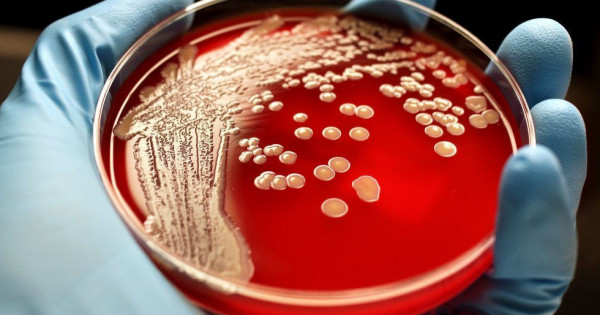

«تۇلكىباس اۋدانىنىڭ ەكى تۇرعىنىندا ءسىبىر جاراسى انىقتالدى. قازىر ولاردىڭ ءبىرى اقمولا وبلىسىندا, بىرەۋى تۇركىستان وبلىسىندا ەمدەلۋدە. ناۋقاستاردىڭ جاعدايى تۇراقتى, جاقىن ارادا ولار اۋرۋحانادان شىعارىلادى», دەپ حابارلادى وبلىستىڭ سانيتارلىق-ەپيدەميالىق باقىلاۋ دەپارتامەنتى.
وندا ناۋقاس جانۋارلاردىڭ ەتى جامبىل وبلىسىنان اكەلىنگەندىگى ايتىلعان. قازىرگى تاڭدا ەت قايدان ساتىپ الىنعانى جانە كىم تاسىمالداعانى قاراستىرىلۋدا.
«قۇرمەتتى وبلىس تۇرعىندارى, ەت جانە ەت ونىمدەرىن ۆەتەرينارلىق انىقتاماسى بار, تەكسەرىلگەن جەرلەردەن عانا ساتىپ الۋلارىڭىزدى سۇرايمىز!», دەدى تۇركىستان وبلىسىنىڭ سانيتارلىق-ەپيدەميالىق دەپارتامەنتى.
ايانا توعانبەك





































